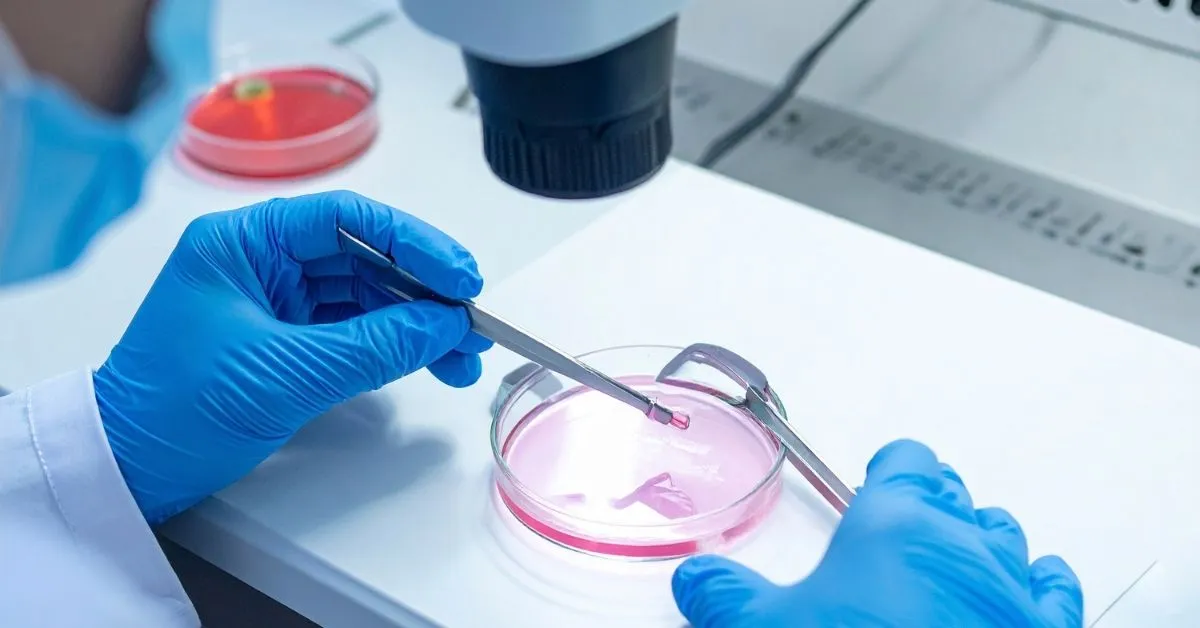

Having a baby is the biggest dream established by many couples. However, sometimes nature needs a little help for this miracle to happen. Called In Vitro Fertilization (IVF) in the medical world and known among the public as Test Tube Baby Treatment, this is the most advanced assisted reproductive technique offered to couples by reproductive medicine.
As Assoc. Prof. Dr. Cengiz Andan Clinic, we stand by families longing for children on this sensitive journey; we maximize the chance of success with the latest technologies and personalized protocols. So, exactly how does this process work? Is it a process to be feared? Here is the step-by-step IVF guide.
IVF, in its simplest definition, is the fertilization of the egg cell (oocyte) taken from the woman and the sperm cell taken from the man in a laboratory environment outside the body, and the transfer of the resulting embryo into the mother’s womb.
While this method was applied only to women with “blocked tubes” in the past, today it offers a solution across a much wider spectrum:

Although IVF treatment varies according to the couple’s condition, it is usually completed within one menstrual cycle (approximately 15-20 days).
Step 1: Preparation and Ovarian Stimulation Treatment usually begins on the 2nd or 3rd day of menstruation. If no problem is seen in the ultrasound check, hormone injections are started to stimulate the ovaries. The goal is to develop multiple eggs instead of the single egg produced every month in a normal cycle, thereby increasing the chance of success. This process takes about 8-10 days, and the patient is called to the clinic at certain intervals to monitor egg development.
Step 2: Egg Collection (OPU – Oocyte Pick Up) When the eggs reach the desired size (usually 17-20 mm), a “cracking injection” is administered. Egg collection is performed approximately 35-36 hours after this injection. Since this procedure is performed under light anesthesia (sedation), the patient feels no pain. The ovaries are entered with a thin needle accompanied by vaginal ultrasound, and the fluids inside the follicles are aspirated to collect the eggs. The procedure takes 15-20 minutes, and the patient can return home on the same day.
Step 3: Laboratory and Fertilization (Microinjection – ICSI) The collected eggs and the sperm samples taken from the male simultaneously are sent to the laboratory. This is where technology and embryologist experience speak. Today, the Microinjection (ICSI) method is generally used instead of classic IVF.
In this method, the highest quality sperm is selected and injected directly into a single egg under a microscope. In this way, the probability of fertilization is maximized.
Step 4: Embryo Culture and Development Monitoring Fertilized eggs are taken under observation in special incubators that mimic the mother’s womb. The division and quality of the embryos are checked every day. Usually, the highest quality embryo on the 3rd or 5th day (blastocyst stage) is selected for transfer. Remaining healthy embryos can be frozen for future use.
Step 5: Embryo Transfer (The Great Meeting) It is the most exciting and easiest stage of the treatment. It does not require anesthesia and is painless. In the gynecological examination position, the selected embryo is gently released into the uterus with the help of a thin catheter accompanied by ultrasound. The procedure takes only 5-10 minutes. 12 days after the transfer, a pregnancy test (Beta HCG) is performed in the blood to learn the result.
IVF treatment is not only a medical process but also a psychological one. The success rate depends not only on laboratory quality but also on the determination of a patient-specific treatment protocol. We adopt the “Personalized Treatment”approach, not a standard dose for every patient. By determining the most appropriate protocol for your ovarian reserve, age, and hormone values, we increase your chances of taking a baby home.
Remember, there is always hope. The important thing is to set out at the right time with the right treatment.
No, the needles used during the treatment process have very fine tips like insulin needles, and the person can administer them to themselves; they do not cause serious pain. Since the egg collection process is performed under anesthesia, pain is not felt. The transfer process is no different from a normal gynecological examination; it does not even require anesthesia.
According to the laws of the Republic of Türkiye, making gender selection (sex determination) in IVF treatment is strictly forbidden. Screening can only be done with genetic testing if there is a medical necessity (risk of sex-linked genetic disease), but arbitrary selection cannot be made.
The success rate varies according to the woman’s age, ovarian reserve, and embryo quality. While the success rate is around 50-60% in women under 35, this rate decreases over the age of 40. However, cumulative success (after several attempts) is much higher.
No, this is a very common misconception. Resting in the clinic for 30-60 minutes after the transfer is sufficient. There is no scientific evidence that constant bed rest after returning home increases the chance of pregnancy. On the contrary, light movement is recommended for blood circulation. You can return to daily life by avoiding heavy work.
Studies conducted in recent years show that the success chance of frozen embryo transfers can be slightly higher than fresh transfers. The reason for this is that after the effect of the drugs used in the egg collection process wears off, the uterus takes a more natural state and is more ready to accept the embryo (Uterine Resting Method).